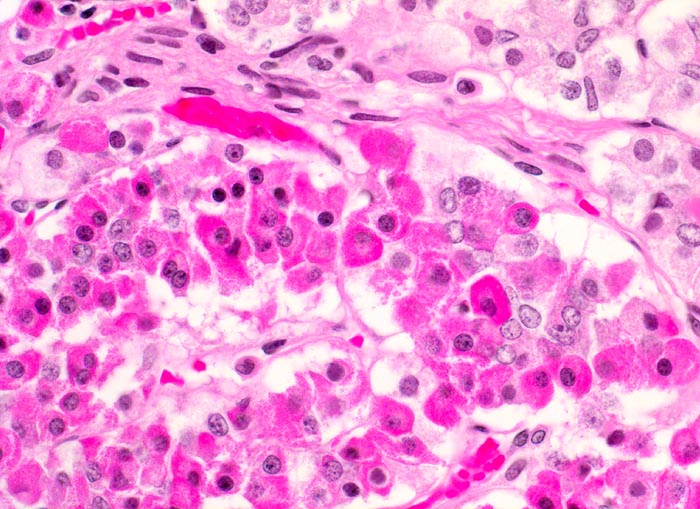

PathoPic – image database / PathoPic ID 4132 - Adenohypophyse
de
Diagnose
Adenohypophyse
Diagnose Gruppe
Normalbefund
Topographie
Hypophyse
Topographie Gruppe
Endokrinium
Beschreibung
Adenohypophyse mit verschiedenen Zelltypen. Die Zellen haben unterschiedlich gefärbtes Zytoplasma. In der HE Färbung können Azidophile, Basophile und Chromophobe Zellen nicht sicher voneinander abgegrenzt werden.
Bilder Typ
Histologie
Vergrösserung
400
Alter
33
Geschlecht
männlich
Datum
Ersteintrag: 04.03.2002
Update: 04.02.2024